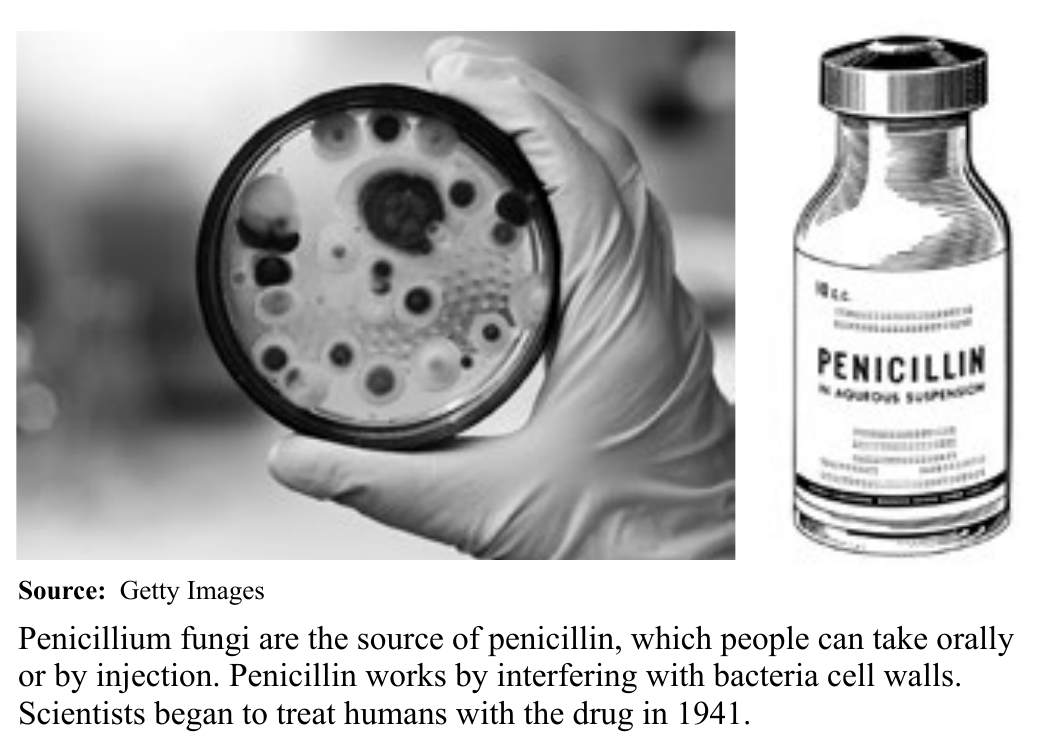
Book illustration

Medical Innovations
A number of advances in medicine have had a dramatic effect on the survival and longevity of humans. Medical research and advancement benefit from, and also inspire, new technologies.
Antibiotics In 1928, Scottish biologist Alexander Fleming was working in his lab in London when he accidentally discovered that a particular fungus produced a substance that killed bacteria. He had discovered penicillin. Penicillin became the first antibiotic, a useful agent in curing bacterial infections. During World War II, antibiotics saved the lives of soldiers who would have died in any previous war from a minor wound that became infected. After the war, antibiotics spread to civilian use, where they fought a range of illnesses.
“I would like to sound one warning,” Fleming said in a speech as he accepted the Nobel Prize. He pointed out that the extensive use of antibiotics carried a risk. By killing off certain strains of a disease, antibiotics allowed the evolution of strains of the disease unaffected by them. These antibiotic-resistant strains could be untreatable. This prospect raised fears of renewed epidemics of diseases once under control.
Reliable Birth Control Another groundbreaking medical advance was in birth control. In the early 1950s, scientist Gregory Pincus developed a birth control pill, a more reliable method than the barrier methods then in use. Scientists tested the pill on women in the 1950s, and the U.S. government approved it for widespread use in 1960.
As a result of the pill and other forms of birth control, fertility rates declined in much of the world. In other words, the average woman began having fewer babies than her mother or grandmother had. Birth control transformed sexual practices and played a part in reshaping gender roles. By 2018, more than 300 million women worldwide were using modern forms of contraception, including the pill.
Vaccines Vaccines have existed since 1796, but governments and nonprofit organizations did not begin developing and widely distributing vaccines to prevent deadly diseases until after 1900. Thanks to vaccines, polio and measles became rare, and smallpox was eradicated by the 1980s. Vaccines are also available to prevent mumps, measles, tetanus, diphtheria, and whooping cough, all potentially serious diseases. As of 2019, a malaria vaccine is in the trial stage.
According to the World Health Organization (WHO), vaccines were preventing as many as 3 million deaths each year in the 21st century. However, the WHO also said that better vaccination coverage would save another 1.5 million people annually. Some people were unable to get vaccinated because they lived in hard-to-reach areas.
